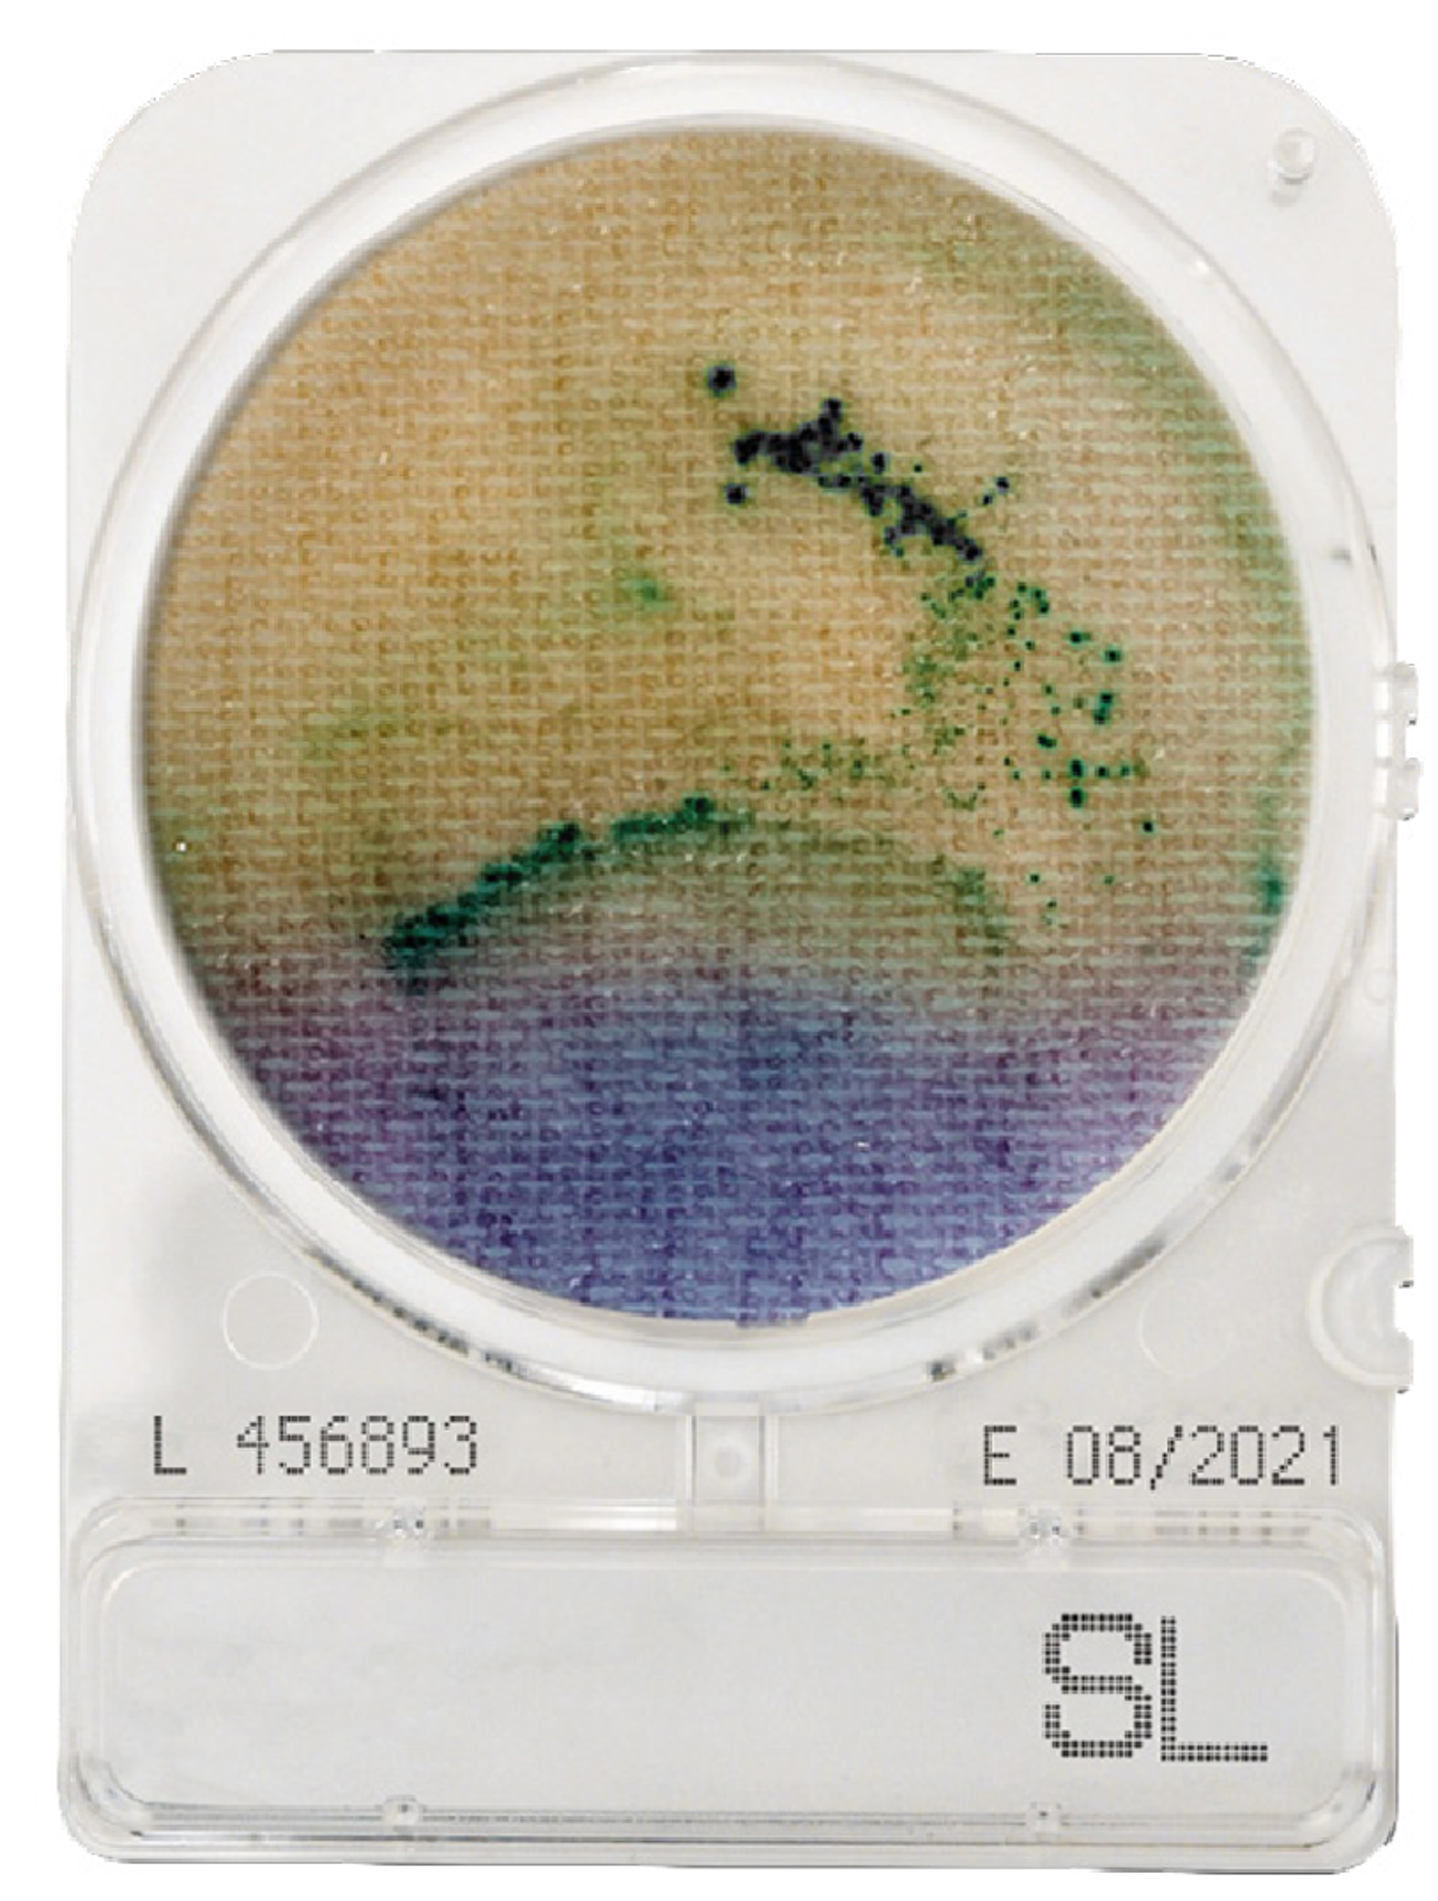

Couldn't load pickup availability
CompactDry SL (Salmonella): Simple and easy to use diagnostic plate used to detect fecal contamination in food products or on surfaces. The plates are fully certified and meet the highest accreditation.
The plates contain a specially formulated media which resuspends in seconds, and generates a colorimetric readout upon successful target identification.
Protocol: CompactDry SL detects salmonella using a 20-24 hour pre-enrichment step. The plates are based on the combination of different test principles:
1. Alkalinisation of the medium, by Salmonella lysine decarboxylase, causes the medium to change colour from blue-purple to yellow. The yellow colouration spreads over the plate due to Salmonella motility.
2. Greening of the colonies is caused by decomposition of chromogenic substrate
by a specific Salmonella enzyme. Black colonies are generated by hydrogen sulphide
producing Salmonella.
Supplied as a pack of 12 units. Store in a cool dark room. Shelf life up to 24 months.
Pack size: 12, 40, 240 or 1400.
Storage: Cool dark room, shelf life up to 24 months.
Delivery: Less than 2 weeks.